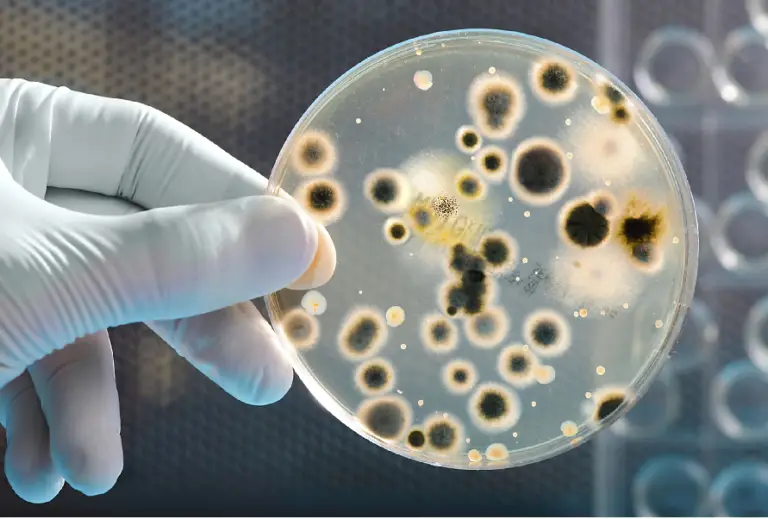
...
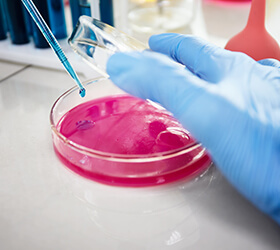
...
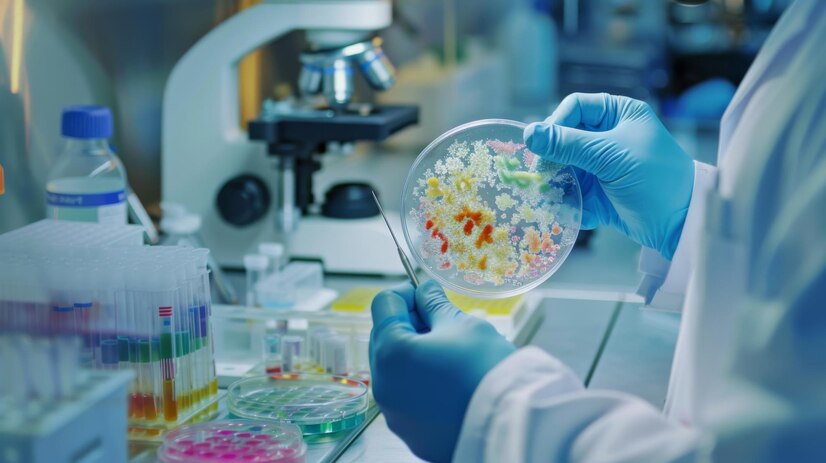
...

Microbiology
Microorganisms and their activities are vitally important to virtually all processes on Earth. Microorganisms matter because they affect every aspect of our lives – they are in us, on us and around us. Eukaryotic microorganisms possess membrane-bound organelles and include fungi and protists , whereas prokaryotic organisms—all of which are microorganisms—are conventionally classified as lacking membrane-bound organelles and include Bacteria and Archaea .
Microbiologists traditionally relied on culture, staining, and microscopy. However, less than 1% of the microorganisms present in common environments can be cultured in isolation using current means. [5] Microbiologists often rely on molecular biology tools such as DNA sequence based identification, for example the 16S rRNA gene sequence used for bacteria identification. Viruses have been variably classified as organisms, as they have been considered either as very simple microorganisms or very complex molecules. Prions , never considered as microorganisms, have been investigated by virologists, however, as the clinical effects traced to them were originally presumed due to chronic viral infections, and virologists took search—discovering "infectious proteins".
The existence of microorganisms was predicted many centuries before they were first observed, for example by the Jains in India and by Marcus Terentius Varro in ancient Rome. The first recorded microscope observation was of the fruiting bodies of moulds, by Robert Hooke in 1666, but the Jesuit priest Athanasius Kircher was likely the first to see microbes, which he mentioned observing in milk and putrid material in 1658. Antonie van Leeuwenhoek is considered a father of microbiology as he observed and experimented with microscopic organisms in the 1670s, using simple microscopes of his own design. Scientific microbiology developed in the 19th century through the work of Louis Pasteur and in medical microbiology Robert Koch. Microbiology is the study of all living organisms that are too small to be visible with the naked eye. This includes bacteria, archaea, viruses, fungi, prions, protozoa and algae, collectively known as 'microbes'. These microbes play key roles in nutrient cycling, biodegradation/biodeterioration, climate change, food spoilage, the cause and control of disease, and biotechnology. Thanks to their versatility, microbes can be put to work in many ways: making life-saving drugs, the manufacture of biofuels, cleaning up pollution, and producing/processing food and drink. Microbiologists study microbes, and some of the most important discoveries that have underpinned modern society have resulted from the research of famous microbiologists, such as Jenner and his vaccine against smallpox, Fleming and the discovery of penicillin, Marshall and the identification of the link between Helicobacter pylori infection and stomach ulcers, and zur Hausen, who identified the link between papilloma virus and cervical cancer. Microbiology research has been, and continues to be, central to meeting many of the current global aspirations and challenges, such as maintaining food, water and energy security for a healthy population on a habitable earth.
- Why Choose Us
- Our Vision
- Our Mission

We provide you with objective information so that you can map your route to fitness and wellness.
Helpful Test Tips
Regulatory surroundings can assist aid sponsors.
Patient Centered Care
Regulatory surroundings can assist aid sponsors.
Microorganisms are beneficial for microbial biodegradation or bioremediation of domestic, agricultural and industrial wastes and subsurface pollution in soils, sediments and marine environments. The ability of each microorganism to degrade toxic waste depends on the nature of each contaminant. Since sites typically have multiple pollutant types, the most effective approach to microbial biodegradation is to use a mixture of bacterial and fungal species and strains, each specific to the biodegradation of one or more types of contaminants. [30] Symbiotic microbial communities confer benefits to their human and animal hosts health including aiding digestion, producing beneficial vitamins and amino acids, and suppressing pathogenic microbes. Some benefit may be conferred by eating fermented foods, probiotics (bacteria potentially beneficial to the digestive system) or prebiotics (substances consumed to promote the growth of probiotic microorganisms). [31][32] The ways the microbiome influences human and animal health, as well as methods to influence the microbiome are active areas of research.
We provide you with objective information so that you can map your route to fitness and wellness.


We provide you with objective information so that you can map your route to fitness and wellness.
